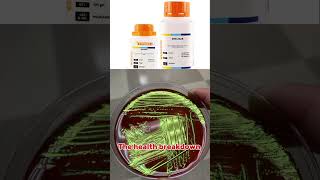

Welcome to The Health Breakdown, the channel where we uncover health truths, debunk dangerous myths, and explain medical topics in the simplest way possible.
From infections like gonorrhea, typhoid, and candidiasis to everyday health mistakes people make — we break it all down with clarity, compassion, and real medical insight.
Our goal is to make health education simple, relatable, and real for everyone — whether you’re in Africa, Europe, Asia, or anywhere in the world.
Here, you’ll learn:
💊 The truth behind common health beliefs
🦠 Causes, symptoms, and real treatments for infections
❤️ Women’s health and hygiene tips
🍎 Natural ways to boost your wellbeing
🧠 Myths that can harm your health — exposed and explained
✅ Subscribe now to stay informed, stay healthy, and see through the lies people believe about health.
Because on this channel — we don’t just talk about health, we break it down! 🔍
Shared 56 years ago
34 views
Shared 56 years ago
40 views
Shared 56 years ago
109 views